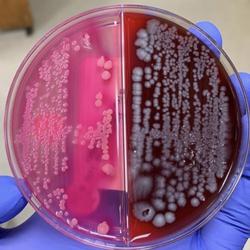

CiCi Moya on Clubhouse

Bio
Digital Marketing|YouTube|SickleCell
📍Haitian-Canadian 🇨🇦🇭🇹
Hi! 👋🏾 I'm CiCi 😄
✨My goal online is to ᴄʀᴇᴀᴛe ᴀ ᴠɪʙʀᴀɴᴛ ᴄᴏᴍᴍᴜɴɪᴛʏ ᴀʀᴏᴜɴᴅ ʜᴏʟɪꜱᴛɪᴄ ʜᴇᴀʟᴛʜ, ʙᴇᴀᴜᴛy, ᴍᴏᴛʜᴇʀʜᴏᴏᴅ, & ʙᴏꜱꜱɪɴɢ ᴜᴘ!✨
👇🏾INVITE ME TO DISCUSS:👇🏾
👠 Tall Girl Life
📲 Content Creation | Digital Marketing
👩👧 Single Motherhood | Mom Life
👩❤️💋👨 Dating | Relationships
🩸 Sickle Cell Treatments & Advocacy
🌱 Natural Remedies | Holistic Healing
📈 Real Estate, Stocks & Crypto
🎞 Film | TV | Acting
🎵 90s-2000s music
LANGUAGES: English, Français, Kreol Ayisyen & Español (slowly lol).
👇🏾MAKE SURE TO FOLLOW ME! 👇🏾
YouTube : CiCi Moya
FB : CiCi Moya Official Page
IG : @cicimoya
Or email me: [email protected]
✨2021=Gratitude+WorkEthic✨
Invited by: Nickkie Moon
Last 10 Records
if the data has not been changed, no new rows will appear.
| Day | Followers | Gain | % Gain |
|---|---|---|---|
| January 31, 2024 | 114 | 0 | 0.0% |
| March 04, 2023 | 114 | +1 | +0.9% |
| September 27, 2022 | 113 | +3 | +2.8% |
| August 07, 2022 | 110 | -1 | -1.0% |
| May 25, 2022 | 111 | +1 | +1.0% |
| April 16, 2022 | 110 | +2 | +1.9% |
| March 09, 2022 | 108 | +1 | +1.0% |
| January 11, 2022 | 107 | +2 | +2.0% |
| December 04, 2021 | 105 | +6 | +6.1% |
| October 26, 2021 | 99 | +4 | +4.3% |